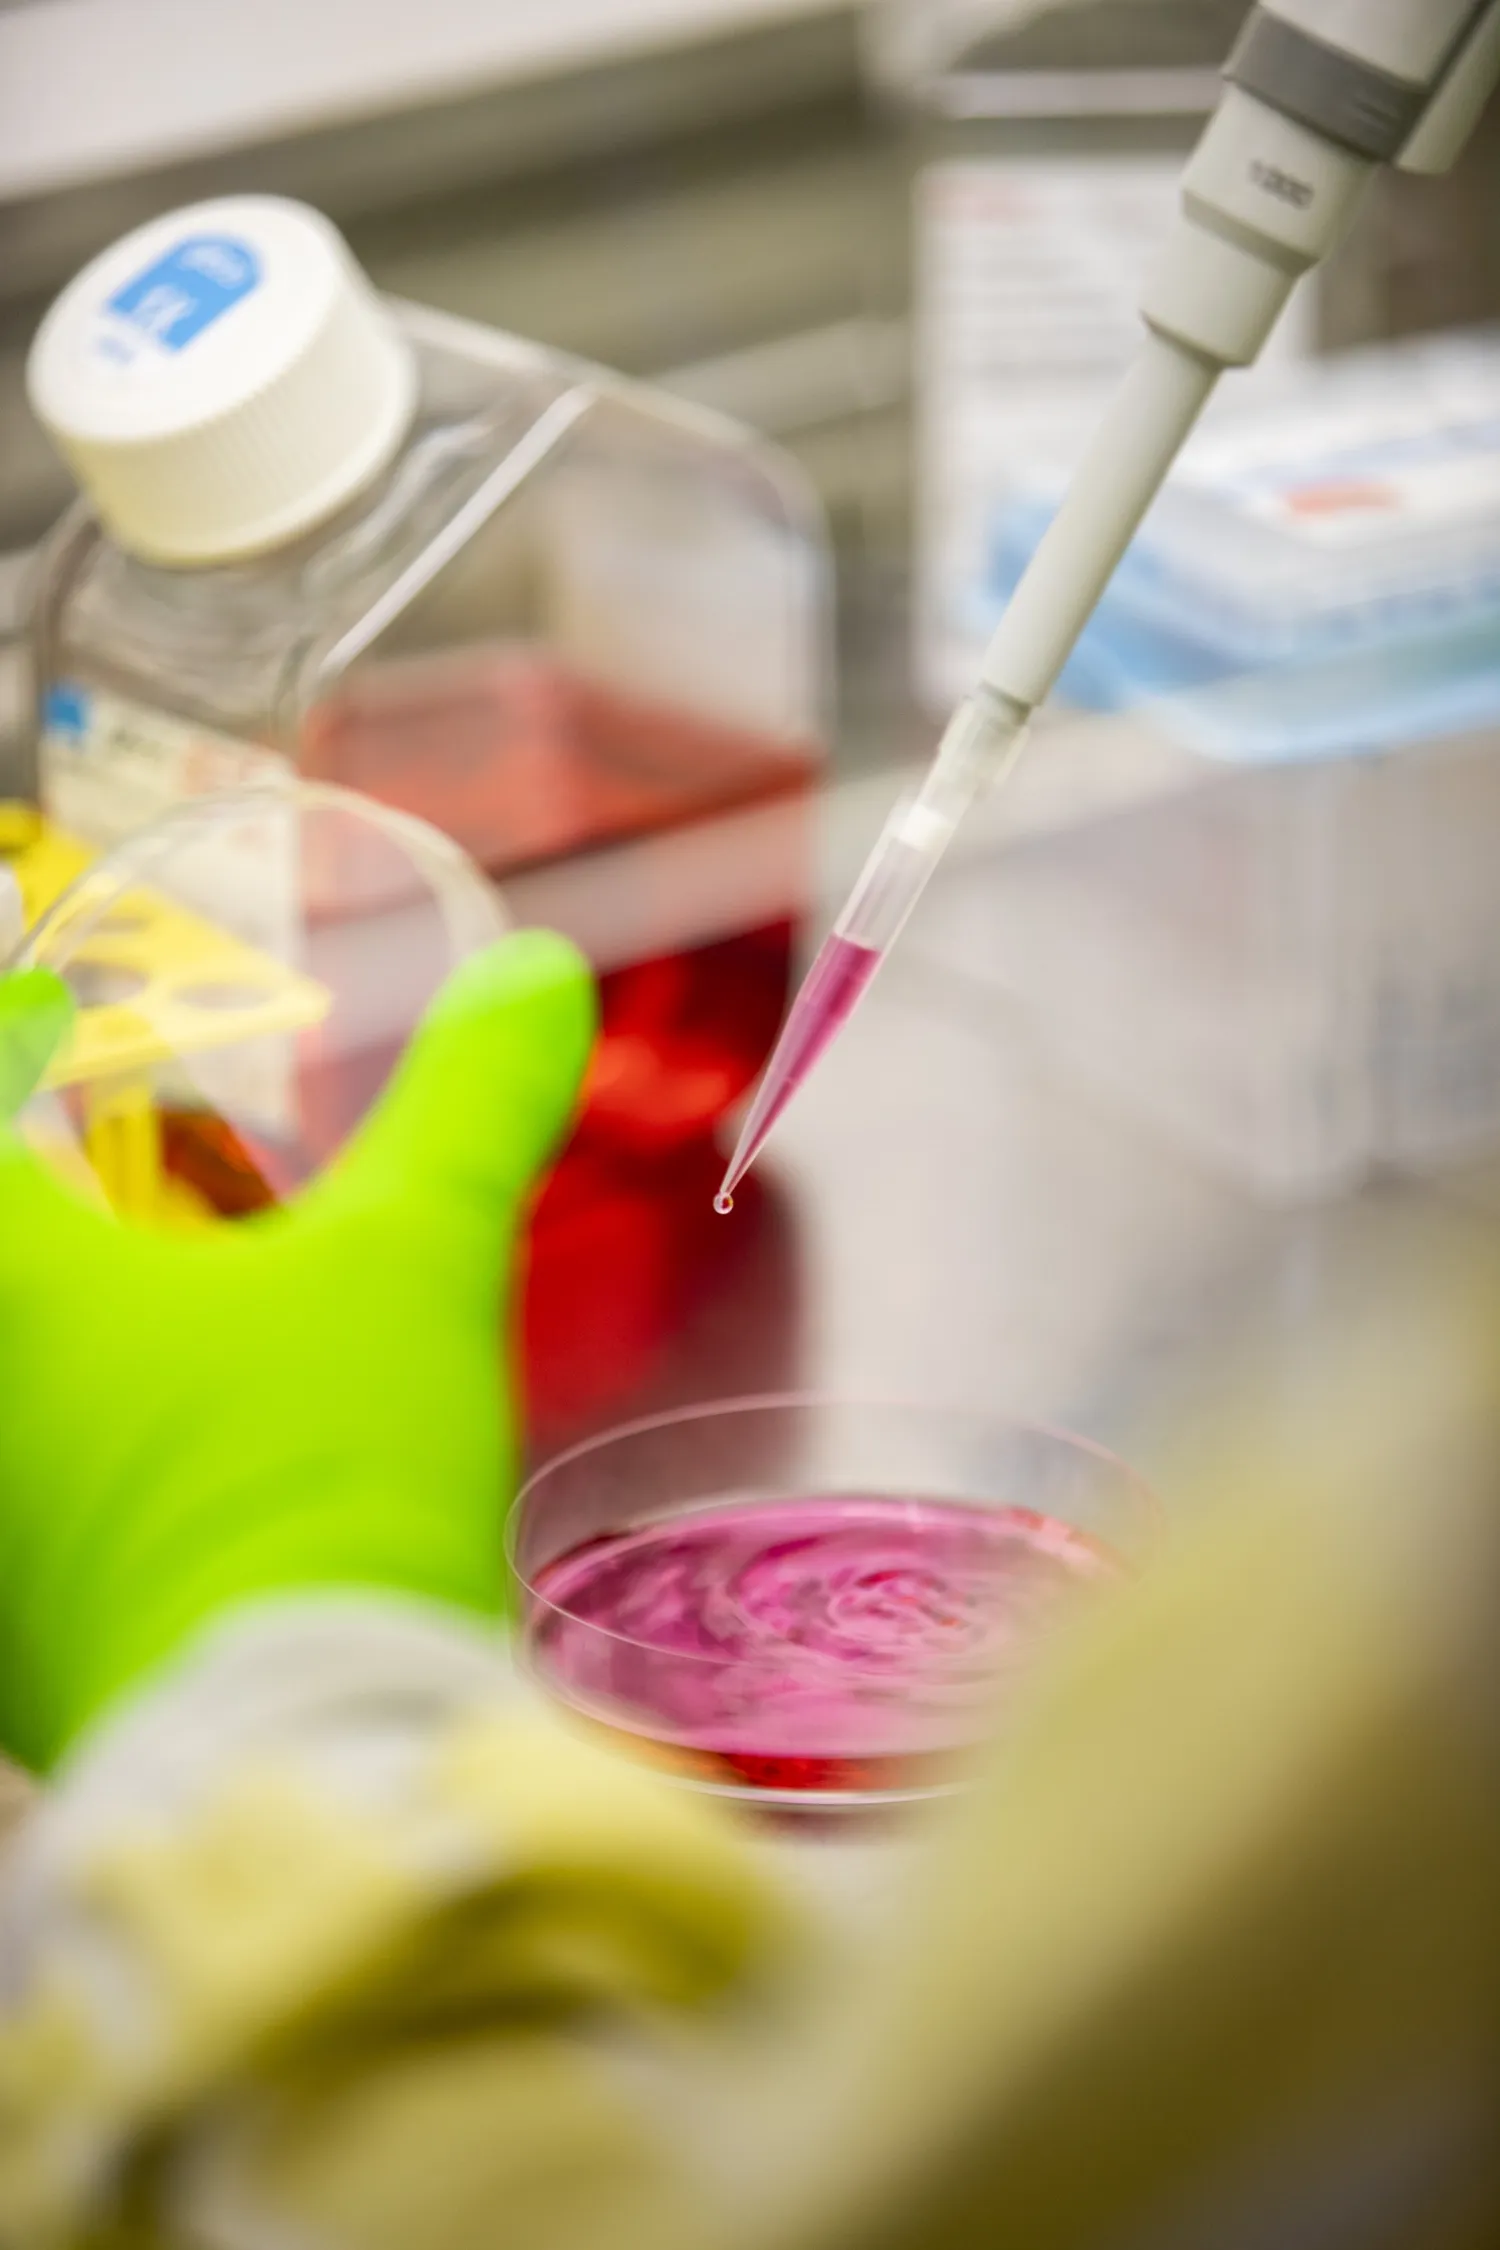
Händer jobbar med pipett och vätska.

Säkerhetskultur på KI
En god säkerhetskultur byggs av flera delar i organisationen. Säkerhetskulturen är viktig för att skapa en medveten organisation, där chefer, medarbetare och studenter bidrar till det heltäckande skyddet för varandra.
Om något händer
- Vid akuta situationer: larma 112
- Ordningsvakt/väktare: Solna: 08-524 864 29, Flemingsberg: 08-524 860 60. De finns tillgängliga på campus, alla dagar, dygnet runt.
- Rapportera händelsen: Rapportera om något hänt.
En god säkerhetskultur består av flera delar: strukturer och arbetssätt, förståelse samt beteende. Målet med god en säkerhetskultur är att skapa en medveten organisation, där chefer, medarbetare och studenter bidrar till det heltäckande skyddet för varandra.
En god säkerhetskultur höjer lägstanivån i organisation och verksamhet och bemöter de behov som finns i vår organisation. Den bidrar också till att organisationen kan gå från en reaktiv till proaktiv nivå.
Faktorer som påverkar säkerhetskulturen
- Att förstärka säkra beteenden genom till exempel uppmuntran och positiv återkoppling.
- Ledningens engagemang: Chefer behöver visa att de prioriterar säkerhetsfrågor för att få engagemang i resten av organisationen.
- Gemensamt ansvar: Att alla tar ansvar är viktigt om man hamnar i en olycks- eller krissituation och för att förebygga olyckor.
- Produktivitet får inte ske på bekostnad av säkerhet. Säkerheten ska prioriteras och det behöver göras en avvägning mellan produktion och säkerhet.
- Involvering: Alla är involverade i hur organisationen kan förbättra säkerheten.
- Rapporteringskultur: Att alla vågar rapportera brister och vågar säga ifrån när fel upptäcks.
- Säkerhetsstyrning: Att det finns föreskrifter och att människor vet vad de ska göra i olika situationer.
Viktiga delar

Fysisk säkerhet på campus
- Använd KI-kort och kod. Bär kortet synligt för allas trygghet.
- Se till att dörren stängs efter dig.
- Följ med besökare till och från möten.
- Okänd person? Våga fråga efter ärende! Titta om personen har KI-kort, alternativt hänvisa till reception.
- Vid upptäckt av obehörig, kontakta väktare.
- Anmäl alltid förlust av nycklar och KI-kort omedelbart till sakerhetsenheten@ki.se.
Mer om förebyggande åtgärder mot inbrott, stöld och skadegörelse.
Brandsäkerhet
- Blockera inte utrymningsvägar eller öppna branddörrar.
- Blockera aldrig vattensprinklers.
- Använd inte privata elektriska produkter som inte är godkända för bruk på KI.
- Använd inte levande ljus i KI:s lokaler.
- Underhåll kablar så att de är i gott skick.
- Undvik förlängningssladdar och seriekoppla inte förlängningssladdar.
Mer information om brandsäkerhet.
Personsäkerhet
- Håll dig uppdaterad kring hur du ska agera vid hot och våld, pågående dödligt våld och terror.
- Var uppmärksam och om du ser avvikelser såsom kvarlämnade väskor, maskerade personer eller personer som uppträder hotfullt - larma områdesväktare och vid akuta situationer 112.
- Vid direkt fara: fly från hotet, sätt dig i säkerhet, varna andra och larma.
Mer information om personsäkerhet.
Resesäkerhet
- För resor till högriskområden ska det göras en särskild riskbedömning.
- Ta endast med dig det du verkligen behöver.
Det finns många tips inför, under och efter en resa, samt hur du bokar en resa på korrekt sätt.
Mer information om säkerhet på resor.
Laboratoriesäkerhet
- Genomför kursen "Introduktion för laboratoriesäkerhet".
- Kontrollera vilka andra utbildningar som krävs för ditt arbete.
- Få en praktisk introduktion på din arbetsplats.
- Genomför/ta del av riskbedömningar för ditt arbete.
- Informera din närmaste chef om du ser säkerhetsbrister.
- Rapportera alltid tillbud och olyckor.
Introduktion till laboratoriesäkerhet: För dig som har din arbetsplats i laboratorium (eller annan verksamhet med liknande risker) är det obligatoriskt att ha genomfört introduktionsutbildningen i laboratoriesäkerhet.
Mer information om laboratoriesäkerhet.
Informationssäkerhet
- Skydda dina inloggningsuppgifter - dela dem aldrig med andra.
- Känslig information måste hanteras i KI:s IT-lösningar.
- Tänk på att hantera personuppgifter enligt kraven i GDPR.
- Tänk på att all internetanvändning loggas. Loggranskning genomförs regelbundet.
- Dela aldrig känslig information om ditt arbete på sociala medier.
Mer information om informationssäkerhet.
IT-säkerhet
- Kom ihåg att datorn är ett arbetsredskap.
- Lås alltid datorn när du lämnar skrivbordet.
- Använd bara godkända IT-lösningar.
- Säkerställ att dina enheter och programvaror är uppdaterade.
- Använd unika lösenord - återanvänd inte lösenord.
- Använd din KI-mejl för arbetsrelaterade saker.
Tänk på! Var eftertänksam innan du:
- använder okända enheter, som USB-minnen.
- svarar på mejl/klickar på länkar/laddar ned dokument från okända avsändare.
Mer information om IT-säkerhet.
Kontakt
Har du frågor eller önskar en utbildning kring säkerhetskultur för er arbetsgrupp, kontakta säkerhetschef Magnus Håkansson.
